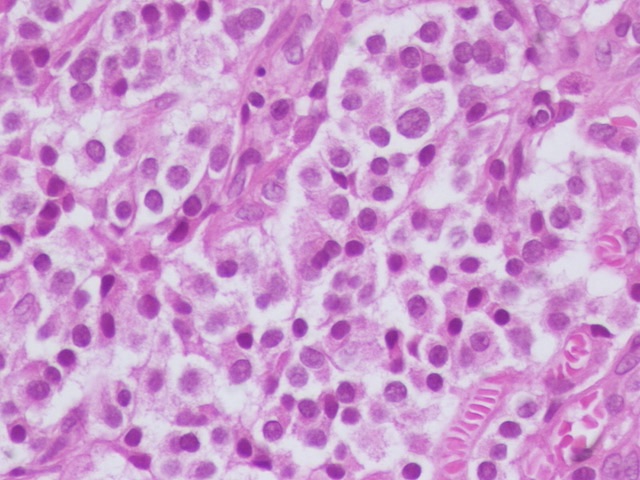

Yale Rosen
@yro854
(#pathologist) with interest in #pulmpath, #foreignbodies ,#sarcoidosis,#granulomas #necrotizingsarcoidgranulomatosis,#lungcancer. #medicalaidindying & others
ID: 949399935006453760
http://www.flickr.com/photos/pulmonary_pathology 05-01-2018 21:59:18
5,5K Tweet
5,5K Followers
358 Following


Dear #GIPath Routine gastric bx ,do you know what these eosinophilic structures are ? I think I saw once here in twitter that can be amyloid like that and a special name to this ?? I think this is called globular amyloidosis ,but have to prove it . Raul S. Gonzalez, MD










Tania Labiano Amparo Benito Berlinches Lara Pijuan,MD PhD,MIAC Sanjay Mukhopadhyay Matthew Cecchini MD PhD FRCPC Ángel Romo Héctor-Enrique Torres-Rivas, MD teresa hermida romer Fábio Tavora, MD, PhD Thin walled cysts that show an abnormal proliferation of spindle-shaped and epithelioid smooth muscle cells that normally express HMB-45, cathepsin K and PR (displayed in order)







They were looking for appendicitis and I only see this 👇👇👇 Not kiwi seed (ruffle surface is much finer adn spaced out here). See Pascual post below. Strawberry seed? 🍓 is in season in Québec now. #PathTwitter #PlantAndSeed Pascual Meseguer Yale Rosen



Yale Rosen Miruna Popescu, MD Celina Stayerman MD Jerad Gardner, MD 212/ Classic case. The empty spaces are a clue to the diagnosis. This diagnosis can 100% be made by pathology alone #pathology #pulmpath #pathx #pathbugs #crittersontwitter #PathTweetAward #idtwitter #tweetcyclopedia

Yale Rosen Ultrastructure with a large round laminated mineralized cytoplasmic body #malakoplakia From Bladder pathology, L. Cheng ISBN 978-0-470-57108-8